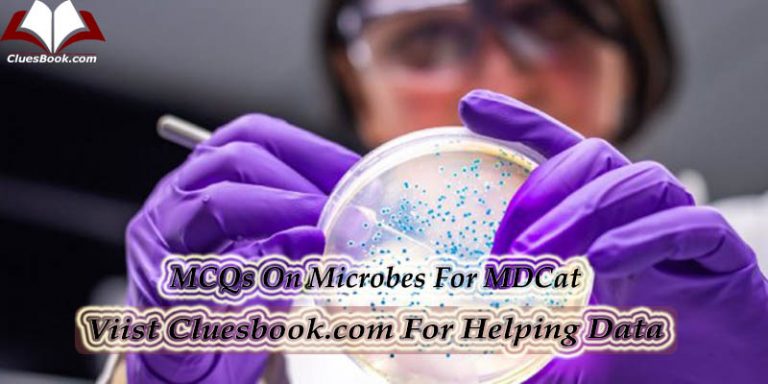
Online MDcat Test Preparation Series Quiz-09

MCQs On Molecular Biology Quiz-1
Download MCQs Molecular Biology Quiz-1 In Pdf From Below Link
Download MCQs Molecular Biology Quiz-1 In Pdf From Below Link

Gaseous Exchange Multiple Choice Questions and Answers Chapter-13 A complex process of oxidation reduction in which food is oxidized to release energy is? A) Reproduction B)Digestion C)Respiration E)Excretion Atmospheric air contains: A) 10% oxygen C) 17% oxygen B)15% oxygen D)21% oxygen E)2% oxygen In higher plants, gas exchange through entire surface of leaves and stem is prevented due to external, waxy covering called. A) Chlorophyll B) Cuticle C)Chitin D) Cellulose …
Q,1). During photophosphorylation, each photon excites …..electron/s? (a) 1 (b) 2 (c) 3 (d) 4 Explanation: A photon is absorbed by chlorophyll pigments surrounding the reaction core center of Photosystem II. The light excites an electron in the pigment P680 at the core of Photosystem II, which is transferred to the primary electron acceptor, pheophytin,…
1. What is the mass of the Sun? 1.5×10 Power 30 Kg 1.98×10 Power 30 Kg✔️ 4.5×10 Power 30 Kg 8×10 Power 30 Kg 2. Which of the following planets is fastest rotating planet? Mercury Marx Jupiter✔️ Venus 3. What is the temperature at the center of the Sun? 6 million °C 10…
1. Cell organelles involved in synthesis of protein hormones are —————— . a. Smooth endoplasmic reticulum b. Mitochondria c. Golgi bodies d. None of above 2. Cholesterol side chain cleavage reaction in the biosynthesis of steroid hormones occurs in——————–. a. Mitochondria b. Endoplasmic reticulum c. Golgi bodies d. Secretory granules 3. The hypothalamic magnocellular neurosecretary…
1. Which of the following is a common Gram-positive bacteria a) Rhizobium of root nodules b) Lactobacillus in curd c) Escherichia coli d) none of these Also Prepare: MCQs On Immunology 2.Gram staining is an example of a) Acid fast stain b) Acid stain c) Differential stain d) None of the above 3.Gram…

Here Are Some MCQs on AIDS HIV is thought to have originated from Birds Mosquitos Chimpanzees None of the above How many stages of HIV infection exist? 3 2 1 No stages SIV is the abbreviation of: Siluridae immunodeficiency virus Simian immunodeficiency virus Synodontidae immunodeficiency virus None of the above HIV…

Some Important On Vitamins For MDCat Q1. Human blood contains ___ percentage of plasma ? A. 35% B. 40% C. 50% D. 65% Q2. How many bones are there in a newly born infant ? A. 206 B. 230 C. 280 D. 300 Q3. A Person having which of the following blood group…
☆1: Classification Of Animals And Plants Is Called__? A: Ecology B: Taxonomy(☆) C: Botany ☆2: All Living Things Are Divided Into____Main Kingdoms. A: Five(☆) B: Four C: Three ☆3: Bacteria Are Very ____Organisms. A: Big B: Fat C: Small(☆) ☆4: Plant Diseases Such as Citrus Canker Are Caused By? A::Fungi B::Algae(☆) C:…

Here Are Some MCQs On Evolution 1. The force that initiates evolution is ______ Variation Extinction Mutation Adaptation 2. ___________ is a vestigial organ Intestinal villi Papillae Vermiform appendix None of the above 3. The earliest geological time period among the following is _______ Permian Cambrian Jurassic Quaternary 4. The experiment…

Sarcoplasm has red pigment………. a Actin b Myosin c Hemoglobin d Myoglobin Tendons are composed of protein………… a Collagen b Myoglobin c Myosin d Actin Bio conversion is digestion of wastes by bacteria which produce ? Propane Butane Methane Ethane The chemical wastes from industry are called ? Effluent Sewage Emission Garbage The…